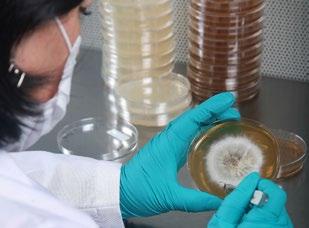

8 minute read
CENTRO DE SEMILLAS Y ÁRBOLES FORESTALES: TREINTA AÑOS DE APORTE A LA INVESTIGACIÓN EN RESTAURACIÓN DE ECOSISTEMAS NATIVOS
El Centro de Investigación Aplicada Productor de Semillas y Árboles Forestales (CESAF), es una unidad de desarrollo e investigación con 30 años de experiencia en especies leñosas, con énfasis en flora nativa con problemas de conservación. Su objetivo es generar conocimiento aplicado en la identificación, colecta, procesamiento, análisis, almacenamiento y desarrollo de tratamientos pregerminativos de semillas para su propagación como parte de iniciativas de restauración, incluyendo análisis ambiental y genético para cumplir el objetivo planteado.
CESAF surge de la motivación de investigadores del Departamento de Silvicultura de la Facultad de Ciencias Forestales, en particular del profesor Rodolfo Gajardo (QEPD), que luego de años dedicados al estudio de la flora leñosa nativa amenazada de extinción y de su propagación y plantación, habían concluido que la semilla es la variable clave del bosque natural y de la diversificación de las plantaciones forestales. Por lo anterior, el 26 de abril de 1993, el Proyecto FONDEF-CONICYT FI-12 permitió el inicio legal de las actividades del centro.
Advertisement
Preocupados por los impactos del cambio climático sobre el bosque nativo, especialmente en lo referido a la capacidad de reproducción y reclutamiento de las especies nativas bajo los escenarios de restricción hídrica e incremento de temperaturas, CESAF en los últimos años ha enfocado su quehacer hacia el desarrollo de investigación aplicada en materia de restauración de ecosistemas forestales del centro norte de nuestro país, con un enfoque basado en consideraciones de sitio, genéticas y silvícolas. Este enfoque se ha traducido en la adjudicación y ejecución de diversos proyectos con financiamiento público, así como colaboraciones y convenios de trabajo con actores públicos y privados.
A continuación, se presenta una breve reseña de los más recientes proyectos desarrollados por el equipo CESAF en el ámbito de la restauración.
Instalaciones del Centros de Semillas y Árboles Forestales al interior de la Facultad de Ciencias Forestales y de la Conservación de la Naturaleza de la Universidad de Chile, en la comuna de La Pintana, Región Metropolitana.
CONSIDERACIONES GENÉTICAS Y SILVÍCOLAS PARA LA RESTAURACIÓN DE BOSQUES HIDRÓFILOS DE QUEBRADA EN LA REGIÓN METROPOLITANA (2020)
Proyecto de investigación actualmente en ejecución y financiado por Fondo de Investigación del Bosque Nativo de la Ley 20.283, su objetivo es evaluar mediante ensayos genéticos y silvícolas métodos de restauración pasiva y activa de bosques hidrófilos de quebrada de la Región Metropolitana. Los ensayos genéticos buscan determinar la existencia de variabilidad genética asociada a la supervivencia y crecimiento inicial de tres localidades de lingue, belloto, patagua y peumo.
En marco de ejecución del proyecto durante 2022 se instalaron ensayos procedencias y restauración activa en la Reserva Natural Altos de Cantillana, los que serán evaluados luego de una temporada en crecimiento y sobrevivencia. La investigación plantea como hipótesis una posible similitud genética entre las poblaciones de las especies estudiadas, dada la reducida distribución en su límite septentrional, por lo que se esperaría que las distintas localidades presenten un similar desempeño en crecimiento y sobrevivencia en un ambiente común. Esto permitiría restaurar ecosistemas azonales con material vegetal de otras procedencias, considerando que las poblaciones son reducidas, están desconectadas, y se presenta una pérdida reciente de algunas de las especies.
El proyecto identificará áreas prioritarias de restauración del bosque hidrófilo, además de caracterizar la situación actual del subtipo forestal, junto a la identificación de posible fuentes semilleras y áreas de conservación. Se espera disponer de un índice de calidad de bosque que permita cuantificar la producción de semillas de la zona, su calidad, y el nivel de regeneración para cada especie, determinando si la cantidad de semillas y su calidad son suficientes para la demanda de material en programas de restauración. Con esta información se tendrá una aproximación a la resiliencia/degradación del sistema en general, permitiendo monitorear el avance de las actividades de restauración ambiental.
Propuesta De Procedencias E Implementaci N De Dos Reas
Productoras De Semillas De Quillay Para Mejorar La Disponibilidad Y Calidad Gen Tica De Semillas
Proyecto financiado por el Fondo de Investigación del Bosque Nativo de la Ley 20.283 y ejecutado entre los años 2012 y 2015 dirigido por el profesor Dr. Carlos Magni, su objetivo fue la identificación de áreas de procedencia agrupadas desde el punto de vista climático, la caracterización de la estructura de las poblaciones y la respuesta temprana de la especie bajo estrés hídrico. Quillay es una especie extensamente distribuida en el territorio nacional, con presencia entre las regiones de Coquimbo y La Araucanía, siendo uno de los principales componentes de las formaciones vegetacionales del bosque esclerófilo.
Las proyecciones de desempeño bajo un escenario de cambio climático permiten aseverar que la especie permanecerá en las áreas que actualmente habita y que podría desplazar levemente su nicho hacia el sur de su distribución. La determinación de la estructura genética expuso que quillay muestra un bajo rango de diversidad genética, la cual se extiende de forma no estructurada en su zona actual de distribución. También se comprobó que la especie presenta mayor variación dentro de sus poblaciones y una menor entre sus poblaciones, lo cual es coincidente en el comportamiento de las especies leñosas de amplia distribución.
La interpolación espacial de la diversidad genética confirmó que la distribución de este parámetro no responde a patrones geográficos, con áreas de mayor concentración de diversidad que coinciden con zonas de alta actividad humana. El empleo de datos genéticos espacialmente explícitos presenta un gran potencial que no ha sido explorado en extenso hasta la fecha, siendo de gran ayuda en la planificación de la conservación a nivel territorial. El análisis morfológico se realizó a más de 84 poblaciones de toda su distribución natural y mostró una falta de variación fenotípica y ninguna asociación del área foliar con el clima en las poblaciones naturales bajo estudio. Sin embargo, las relaciones significativas entre los pecíolos y las nervaduras con las variables climáticas sugieren que los pecíolos más cortos y las nervaduras más delgadas son adaptaciones de las poblaciones ubicadas en sitios secos para enfrentar un transporte de agua restringido y mayores tasas de transpiración. Es una especie altamente plástica, que no presenta diferencias estadísticas importantes en su morfología.

La especie muestra una gran plasticidad frente a las restricciones hídricas. Se destaca que la variable procedencia muestra diferencias frente al desempeño bajo condiciones restrictivas. Este estudio mostró que, con la excepción de las procedencias Coquimbo Interior (árido norte) y Maule Interior (subhúmedo central), el resto de las nueve procedencias de Q. saponaria mostraron un comportamiento uniforme en ambos tratamientos de riego a nivel morfológico y fisiológico. Este desempeño estable en características funcionales importantes en la etapa de vivero podría indicar el potencial para el despliegue de genotipos de Q. saponaria con alta estabilidad en una amplia gama de ubicaciones. La importancia ecológica de los resultados implica que la procedencia debe incluirse en el diseño de programas de restauración forestal y que la translocación de procedencias de Q. saponaria más allá de sus límites ecológicos locales debe considerarse cuidadosamente. Esto es de suma importancia a considerar en planes de restauración, debido a que en ellos se busca la sobrevivencia en terreno, pero además buen crecimiento y producción de biomasa.
Distribución natural de quillay e identificación de puntos de muestreo para la caracterización y toma de muestras para el desarrollo de los objetivos del proyecto. A la derecha, estados fenológicos identificados para la caracterización de las APS en el Parque Precordillerano Cantalao (Área Productora de Semilla potencial). F.- Flor central y laterales cerradas.; G.-Detalle de la flor central y flores laterales en extensión. H.- Flor central abierta y estambres internos extendiéndose.; I.- Comienzo de ambos verticilos de estambres en extensión.; J.- Dehiscencia de las anteras y formación de frutos.
REGENERACIÓN DE BEILSCHMIEDIA MIERSII
(BELLOTO DEL NORTE) SEGÚN CONTENIDO
HÍDRICO DEL SUELO Y PRESENCIA DE HOJARASCA
Durante el periodo 2012 y 2014 se desarrolló este proyecto con financiamiento CONAF/FIBN dirigido por el profesor de la casa de Bello Dr. Gabriel Mancilla, en el sector de Altos de Chocalán perteneciente a la Reserva Natural privada Altos de Cantillana, Región Metropolitana. Belloto es una especie nativa endémica que distribuye de forma fragmentada entre las regiones de Valparaíso y O’Higgins, ocupando zonas que experimentan cambios en su hábitat debido a las presiones antrópicas y ambientales por los efectos del cambio climático, que han llevado a que se encuentre en categoría de conservación vulnerable.
En el marco del proyecto se establecieron ensayos y estrategias que comprendían la propagación de la especie y los factores que la afectan, como son la estructura del bosque, su genética, las dinámicas hídricas y térmicas de los suelos y cómo estas variables se vinculaban a la germinación de las semillas, su establecimiento y posterior desarrollo de las plantas en su hábitat natural. El conocer estos factores permitió entender y vislumbrar los efectos principales que el ambiente genera en las primeras etapas de la regeneración de la especie, punto crítico para su posterior crecimiento y establecimiento definitivo en el sitio.
Se pudo determinar que la especie presenta buena producción de semillas, pero que luego de su dispersión presenta fuertes presiones por la fauna, debido a su alta palatabilidad; la depredación de sus semillas es uno de los factores que más afecta la continuación de las etapas de colonización de la especie, debido a que reduce de forma importante la existencia de nuevas plantas en el bosque.

De la investigación se extrae además lo esencial que es el cuidado de las primeras capas superficiales del suelo en el bosque, donde se encuentra la hojarasca, ya que es esta la que permite que las semillas permanezcan el tiempo necesario para la germinación, ocultándolas de los herbívoros post dispersión y entregando las condiciones ambientales necesarias para el establecimiento y posterior desarrollo de las plantas al mantener un rango adecuado de humedad en la interfase con el suelo mineral. Se pudo comprobar que la escasez o ausencia de hojarasca en el piso del bosque afecta el éxito de la germinación y el establecimiento de plántulas.
Por otra parte, se comprobó que la sombra y microclima que genera una amplia cobertura boscosa por el contrario, la excesiva apertura del bosque y consiguiente ingreso de luz e incremento de la temperatura ambiente, son también dañinos para la especie. Como medidas factibles de implementar y bonificar para quienes trabajen en la conservación de belloto, está el impedir la extracción de tierra de hojas, favorecer la condición segura para la especie (evitar los grandes claros y excluir el ingreso de animales, especialmente herbívoros), realizar faenas de enriquecimiento y riego de establecimiento, además de controlar especies exóticas agresivas.
Colaboraciones Institucionales
CESAF también ha colaborado en proyectos de rehabilitación de bosque nativo con la Universidad Católica del Maule. En forma reciente participó del proyecto titulado “Contribución a la rehabilitación del Bosque y Matorral Esclerófilo de la Región del Maule” financiado por el Fondo de Investigación del Bosque Nativo de CONAF (Proyecto 015/2017) dirigido por el profesor de esa casa de estudios, Dr. Sergio Espinoza Meza. El proyecto apuntó a superar las barreras que impiden la rehabilitación y restauración del matorral y bosque esclerófilo de la Región del Maule, mediante la evaluación del efecto de distintas técnicas de restauración sobre la supervivencia, crecimiento y desempeño fisiológico de las especies Acacia caven, Quillaja saponaria, Lithraea caustica, Colliguaya odorifera, Escallonia pulverulenta, y Peumus boldus en la Estación Experimental Justo Pastor León en el sector Las Brizas, ubicada en la Región del Maule. Entre las medidas evaluadas se encontraban la calidad de planta en vivero, aporte de mulch orgánico, tubos protectores, plantación en núcleo y riego estival por minitranque. Los resultados indican que las técnicas de apoyo a la restauración (riego de apoyo y tubo protector) permitieron una adecuada supervivencia en campo de la mayoría de las especies en estudio. El factor más importante para lograr el éxito de la restauración fue el riego.
Producci N Cient Fica Y Desarrollo De Formaciones Profesionales
Los proyectos de investigación indicados han permitido a su vez desarrollar una importante producción científica y la formación de capacidades, mediante la incorporación de estudiantes en práctica y el desarrollo de tesis de post y pregrado. Al cuerpo de investigadores que conforman el CESAF, se suma un equipo de egresados y estudiantes que ven enriquecida su formación participando de las actividades en terreno de los distintos proyectos bajo ejecución.